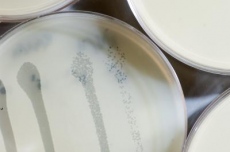

Antropología
El sentido evolutivo de la expresión facial de enfado
Cuando una persona, sea de la cultura que sea, muestra el enfado en su cara, la expresión facial que adopta posee unos mismos rasgos que son comunes a la expresión de enfado de cualquier otro ser humano. La expresión es universal desde el punto de vista cultural, e incluso niños ciegos congénitos ponen esta misma cara al enfadarse sin haber nunca visto ninguna. ¿Por qué el enfado nos hace adoptar esa expresión y no otra? ¿Qué tiene de especial para que se asocie tanto a esa emoción y no a otra? En una investigación se ha dado con una posible explicación.
Unos científicos de la Universidad de California en Santa Bárbara, Estados Unidos, y la Universidad Griffith en Australia, han identificado el origen y la utilidad atávica de la expresión facial del enfado.
La expresión de enfado emplea siete grupos distintos de músculos que se contraen de una manera muy característica. El equipo de Aaron Sell, de la Escuela de Criminología en la Universidad Griffith, se propuso averiguar por qué la evolución eligió esas contracciones musculares en particular para señalar el estado emocional del enfado.
Partiendo de la hipótesis de que la expresión de enfado surgió en la evolución para resultar intimidatoria, los investigadores razonaron que cuando la persona adopta esta expresión facial, el primer paso es comunicar a su adversario que lo que ha producido el enfado no es aceptable, y que el conflicto no finalizará hasta que se alcance un acuerdo implícito. Esta es la razón por la cual la emoción del enfado tiene una expresión facial inequívoca asociada a ella.
![[Img #22012]](upload/img/periodico/img_22012.jpg)
La expresión facial de enfado es tan universal, que cualquiera puede reconocerla hasta en el más simple de los dibujos, y además parece que su función ancestral, forjada por la evolución, es hacer parecer más fuerte a la persona enfadada. (Imagen: Amazings / NCYT / JMC)
Pero la cara de enojo no solo señala el comienzo de un conflicto. Cualquier expresión facial característica podría hacer eso. El aspecto clave, que marca la conclusión a la que ha llegado el equipo de Sell, es que la cara de enfado desarrolló su forma específica porque proporciona algo más para el que la expresa: Cada elemento está diseñado para ayudar a intimidar a los oponentes, haciendo que el individuo enfadado parezca más capaz de hacer daño si se le sigue desafiando. Para nuestros antepasados, tal como argumenta Leda Cosmides del equipo de investigación, una fortaleza más grande en la parte superior del cuerpo llevó a una mayor capacidad de infligir daños; así que la hipótesis que estos científicos proponen es que la expresión facial de furia surgió en la especie humana porque hace que la persona parezca más robusta, y por ende, más peligrosa.
Usando caras generadas por ordenador, los investigadores han demostrado que cada uno de los componentes individuales de una expresión facial de enfado hizo que esas personas generadas informáticamente parecieran físicamente más fuertes.